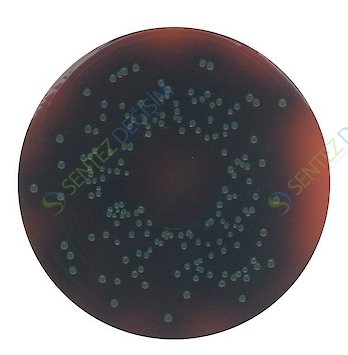
MERCK 111755.0500 Palcam Listeria-Selective Agar (Base) Acc. To Van Netten Et Al. For Microbiology

MERCK 111755.0500 Palcam Listeria-Selective Agar (Base) Acc. To Van Netten Et Al. For Microbiology
| Description |
|---|
| Catalogue Number | 111755 |
| Product Information |
|---|
| HS Code | 3821 00 00 |
| Quality Level | MQ200 |
| Physicochemical Information |
|---|
| pH value | 6.9 - 7.1 (68.8 g/l, H₂O, 25 °C) (after autoclaving) |
| Bulk density | 650 kg/m3 |
| Solubility | 68.8 g/l |
| Safety Information according to GHS |
|---|
| Hazard Statement(s) | H315: Causes skin irritation.H319: Causes serious eye irritation. |
| Precautionary Statement(s) | P264: Wash skin thoroughly after handling.P280: Wear protective gloves/ eye protection/ face protection.P302 + P352: IF ON SKIN: Wash with plenty of water.P305 + P351 + P338: IF IN EYES: Rinse cautiously with water for several minutes. Remove contact lenses, if present and easy to do. Continue rinsing.P332 + P313: If skin irritation occurs: Get medical advice/ attention.P337 + P313: If eye irritation persists: Get medical advice/ attention. |
| Storage class | 10 - 13 Other liquids and solids |
| WGK | WGK 3 highly hazardous to water |
| Disposal | 3Relatively unreactive organic reagents should be collected in container A. If halogenated, they should be collected in container B. For solid residues use container C. |
| Storage and Shipping Information |
|---|
| Storage | Store at +15°C to +25°C. |
| Specifications |
|---|
| Base tested with PALCAM-Listeria selective supplement acc. to VAN NETTEN et.al. art. no. 1.12122. |
| Appearance (clearness) | clear to slightly opalescent |
| Appearance (color) | red |
| pH-value (25 °C) | 7.0 - 7.4 |
| Growth promotion test in accordance with the current version of DIN EN ISO 11133. |
| Inoculum on reference medium (Listeria monocytogenes ATCC 35152 (WDCM 00109)) | |
| Inoculum on reference medium (Listeria monocytogenes ATCC 13932 (WDCM 00021)) | |
| Inoculum on reference medium (Listeria innocua ATCC 33090 (WDCM 00017)) | |
| Colony count (Listeria monocytogenes ATCC 35152 (WDCM 00109)) | |
| Colony count (Listeria monocytogenes ATCC 13932 (WDCM 00021)) | |
| Colony count (Listeria innocua ATCC 33090 (WDCM 00017)) | |
| Recovery on test medium (Listeria monocytogenes ATCC 35152 (WDCM 00109)) | ≥ 50 % |
| Recovery on test medium (Listeria monocytogenes ATCC 13932 (WDCM 00021)) | ≥ 50 % |
| Recovery on test medium (Listeria innocua ATCC 33090 (WDCM 00017)) | ≥ 50 % |
| Growth (Escherichia coli ATCC 25922 (WDCM 00013)) | total inhibition |
| Growth(Escherichia coli ATCC 8739 (WDCM 00012)) | total inhibition |
| Growth (Staphylococcus aureus ATCC 25923 (WDCM 00034)) | partial inhibition |
| Black zone (Listeria monocytogenes ATCC 35152 (WDCM 00109)) | black zone |
| Black zone (Listeria monocytogenes ATCC 13932 (WDCM 00021)) | black zone |
| Black zone (Listeria innocua ATCC 33090 (WDCM 00017)) | black zone |
| Incubation: up to 48 hours at 35 ± 1 °C, aerobicA recovery rate of 50 % is equivalent to a productivity value of 0.5.The indicated colony counts result from the sum of a triple determination.Reference media: Tryptic Soy Agar |